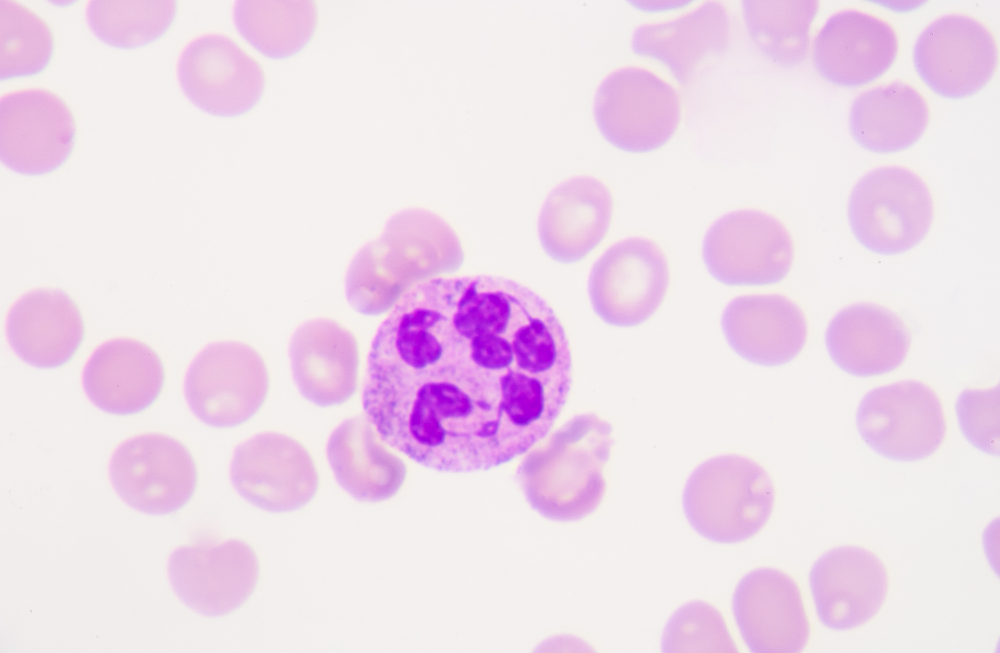

Biomedisan, 2025’te kurulan; sağlık teknolojileri, yapay zeka ve görüntü işleme alanlarında faaliyet gösteren yenilikçi bir girişimdir. Araştırma ekibimiz 2020’den bu yana sürdürdüğü çalışmalarla, TÜBİTAK 1812 Yatırım Tabanlı Girişimcilik Destek Programı kapsamında Mükemmeliyet Mührü’ne layık görülmüştür.

Yapay zeka tabanlı özgün yöntemlerle, görüntü işleme alanında yeni bir yaklaşım geliştiriyoruz. Proje ekibimiz; yapay zeka, gelişmiş görüntü işleme ve yüksek çözünürlüklü görüntüleme teknolojilerini entegre eden bütüncül bir cihaz üzerinde çalışmaktadır. Bu çözüm, kan hücrelerinin analizi ve hastalıkların teşhis süreçlerini optimize eden bir ürün-hizmet portföyü sunar
Hedefimiz; hematoloji uzmanlarının iş yükünü azaltmak, erken teşhisi kolaylaştırmak ve sağlık hizmetlerinde verimliliği artırmaktır.

Ekip Üyeleri
Dr. Öğr. Üyesi Zeynep Rüya EGE – Biyomedikal Müh.
Doç. Dr. Osman Yokuş – Hematoloji Uzmanı
Dr. Öğr. Üyesi Ali Olamat – Görüntü işleme ve Yapay Zeka Uzmanı
Dr. Hasan EGE – Fizyoloji Uzmanı
Kusay Karki – Biyomedikal ve Sistem Tasarım Mühendisi
Çözüm Ortaklarımız
Çözüm ortaklarımızla birlikte sağlık teknolojilerinde yeniliği hızlandırıyoruz. Biomedisan, 2025’te TÜBİTAK 1812 Yatırım Tabanlı Girişimcilik Destek Programı kapsamında Mükemmeliyet Mührü desteğiyle kurulmuş bir Ar-Ge şirketidir.

Kısa sürede, uzun yıllara dayanan birikimimizi bütüncül bir cihazda birleştirerek pazara sunmaya hazırlanıyoruz. Bu yolculukta değer katan iş birlikleri kuruyor, ölçeklenebilir büyüme için yatırımcı görüşmelerimizi de aktif şekilde sürdürüyoruz.

